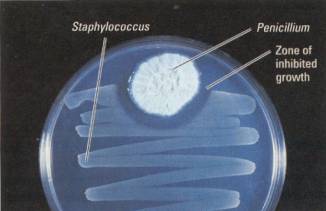

H-Evolution-006Plants
Plants
Colonizing
Land
Plants are terrestrial (land-dwelling)
organisms. True, some, such as water lilies, have returned to the water, but
they evolved secondarily from terrestrial ancestors (as did several species of
aquatic animals, such as porpoises).
A plant is a
multicellular eukaryote that makes organic molecules by photosynthesis.
Photosynthesis distinguishes plants from the animal and fungal kingdoms. Large
algae are also multicellular,
eukaryotic, and photosynthetic. The following are terrestrial adaptations that
distinguishes plants from algae.

Figure
16.2 Contrasting environments for algae and plants
Terrestrial
Adaptations of Plants
Structural
Adaptations Living on land poses very different problems from living in water
(Figure 16.2). In terrestrial habitats, the resources that a photosynthetic
organism needs are found in two very different places. Light and carbon dioxide
are mainly available above-ground, while water and mineral nutrients are found
mainly in the soil. Thus, the complex bodies of plants show varying degrees of
structural specialization into subterranean and aerial organs-roots and
leaf-bearing shoots, respectively.
Most plants have
symbiotic fungi associated with their roots. These root-fungus combinations are
called mycorrhizae ("fungus root"). For their part, the fungi absorb
water and essential minerals from the soil and provide these materials to the
plant. The sugars produced by the plant nourish the fungi. Mycorrhizae are
evident on some of the oldest plant fossils. They are key adaptations that made
it possible to live on land (Figure 16.3).
Leaves are the
main photosynthetic organs of most plants. Exchange of carbon dioxide and
oxygen between the atmosphere and the photosynethic interior of a leaf occurs
via stomata, the microscopic pores through the leafs surface (see Figure 7.3).
A waxy layer called the cuticle coats the leaves and other aerial parts of most
plants, helping the plant body retain its water. (Think of the waxy surface of
a cucumber or unpolished apple.)
Differentiation
of the plant body into root and shoot systems solved one problem but created
new ones. For the shoot system to stand up straight in the air, it must have
support. This is not a problem in the water: Huge seaweeds need no skeletons
because the surrounding water buoys them. An important terrestrial adaptation
of plants is lignin, a chemical that hardens the cell walls. Imagine what would
happen to you if your skeleton were to disappear or suddenly turn mushy. A tree
would also collapse if it were not for its "skeleton”, its framework of
lignin-rich cell walls.

Figure 16.3 Mycorrhizae: symbiotic associations of fungi and
roots. The finely branched filaments of the fungus provide an extensive surface
area for absorption of water and minerals from the soil. The fungus provides
some of those materials to the plant and benefits in turn by receiving sugars
and other organic products of the plant's photosynthesis.
Figure 16.4 Network of veins in a leaf. The vascular tissue of the
veins delivers water and minerals absorbed by the roots and carries away the
sugars produced in the leaves.
Specialization of
the plant body into roots and shoots also introduced the problem of
transporting vital materials between the distant organs. The terrestrial
equipment of most plants includes vascular tissue, a system of tube-shaped
cells that branch throughout the plant (Figure 16.4). The vascular tissue
actually has two types of tissues specialized for transport: xylem,
consisting of dead cells with tubular cavities for transporting water and
minerals from roots to leaves; and phloem, consisting of living cells
that distribute sugars from the leaves to the roots and other nonphotosynthetic
parts of the plant.
Reprodudive
Adaptations Adapting to land also required a new mode of reproduction. For
algae, the surrounding water ensures that gametes (sperm and eggs) and
developing offspring stay moist. The aquatic environment also provides a means
of dispersing the gametes and offspring. Plants, however, must keep their
gametes and developing offspring from drying out in the air. Plants (and some
algae) produce their gametes in protective structures called gametangia
(singular, gametangium). A gametangium has a jacket of protective cells
surrounding a moist chamber where gametes can develop without dehydrating.
In most plants, sperm reach the eggs
by traveling within pollen, which is carried by wind or animals. The egg
remains within tissues of the mother plant and is fertilized there. In plants,
but not algae, the zygote (fertilized egg) develops into an embryo while still
contained within the female parent, which protects the embryo and keeps it from
dehydrating (Figure 16.5). Most plants rely on wind or animals, such as
fruit-eating birds or mammals, to disperse their offspring, which are in the
form of embryos contained in seeds.
The reproductive
"strategy" of plants is analogous to how mammals manage to reproduce
on land. As in plants, mammalian fertilization is internal ( within the
mother's body). And in most mammals, embryonic development also occurs within
the mother's body, as it does in plants.
The
Origin of Plants from Green Algae
The move onto land and the spread of
plants to diverse terrestrial environments was incremental. It paralleled the
gradual accumulation of terrestrial adaptations, beginning with populations
that descended from algae. Green algae are the protists most closely related to
plants. More specifically, molecular comparisons and other evidence place a
group of multicellular green algae called charophyceans closest to plants
(Figure 16.6).
The evolutionary "walk"
onto land was more like adaptive baby steps. Many species of modern
charophyceans are found in shallow water around the edges of ponds and lakes.
Some of the ancient charophyceans that lived about the time that land was first
colonized may have inhabited shallow-water habitats subject to occasional
drying. Natural selection would have favored individual algae that could
survive through periods when they were not submerged. The protection of
developing gametes and embryos within jacketed organs (gametangia) on the
parent is one adaptation to living in shallow water that would also prove
essential on land. We know that by about 475 million years ago, the vintage of
the oldest plant fossils, an accumulation of adaptations allowed permanent
residency above water. The plants that color our world today diversified from
those early descendants of green algae.

Figure 16.5 The protected
embryo of a plant. Internal fertilization with sperm and egg combining without
a moist chamber on the mother plant, is an adaptation for living on land. This
female parent continues to nurture and protect the plant embryo which develops
from the zygote.
Figure 16.6 Charophyceans, closest algai relative to plants. (a)
Chara is a particularly elaborate green alga. (b) Coleochaete though less
plantlike than Chara in appearance, is actually more closely related to plants.
Highlights
of Plant Evolution
The fossil record chronicles four major periods
of plant evolution, which are also evident in the diversity of modern plants
(Figure 16.7) .Each stage is marked by the evolution of structures that opened
new opportunities on land.
The first period
of evolution was the origin of plants from their aquatic ancestors, the green
algae called charophyceans. The first terrestrial adaptations included
gametangia, which protected gametes and embryos. This made it possible for the
plants known as bryophytes, including the mosses, to diversify from early plants.
Vascular tissue also evolved relatively early in plant history. However, most
bryophytes lack vascular tissue, which is why they are categorized as
nonvascular plants.
The second period
of plant evolution was the diversification of vascular plants (plants with
vascular tissue that conducts water and nutrients). The earliest vascular
plants lacked seeds. Today, this seedless condition is retained by ferns and a
few other groups of vascular plants.
The third major
period of plant evolution began with the origin of the seed. Seeds advanced the
colonization of land by further protecting plant embryos from desiccation (
drying) and other hazards. A seed consists of an embryo packaged along with a
store of food within a protective covering. The seeds of early seed plants were
not enclosed in any specialized chambers. These plants gave rise to many types
of gymnosperms ("naked seed"). Today, the most widespread and diverse
gymnosperms are the conifers, which are the pines and other plants with cones.
The fourth major
episode in the evolutionary history of plants was the emergence of flowering
plants, or angiosperms ("seed container"). The flower is a complex
reproductive structure that bears seeds within protective chambers (containers)
called ovaries. This contrasts with the bearing of naked seeds by gymnosperms.
The great majority of modern-day plants are angiosperms.
There are four
major groups of modern plants: obryophytes, ferns, gymnosperms, and
angiosperms. Bryophytes
The most familiar
bryophytes are mosses. A mat of moss actually consists of many plants growing
in is a tight pack, helping to hold one another up (Figure 16.8). The mat has a
spongy quality that enables it to absorb and retain water.
Mosses are not
totally liberated from their ancestral aquatic habi!at. They do display two of
the key terrestrial adaptations that made the move onto land possible: a waxy
.cuticle that helps prevent dehydration; and the retention of developing
embryos within the mother plant's gametangium. However, mosses need water to
reproduce. Their sperm are flagellated, like those of most green algae. These
sperm must swim through water to reach eggs. (A film of rainwater or dew is
often enough moisture for the sperm to travel.) In addition, most mosses have
no vascular tissue to carry water from soil to aerial parts of the plant. This
explains why damp, shady places are the most common habitats of mosses. These
plants also lack lignin, the wall-hardening material that enables other plants
to stand tall. Mosses may sprawl as mats over acres, but they always have a low
profile.

Figure 16.7 Highlights of plant evolution. Modern representatives of the major
evolutionary branches are illustrated at the top of this phylogenetic tree. As
we survey the diversity of plants. Miniature versions of this tree will help
you place each plant group in its evolutionary context.
If you look
closely at some moss growing in your vicinity, you may actually see two
distinct versions of the plant. The greener, spongelike plant that is the more
obvious is called the gametophyte. You may see the other version of the moss,
called a sporophyte. growing out of a gametophyte as a stalk with a capsule at
its tip (Figure 16.9) .The cells of the gametophyte are haploid (one set of
chromosomes). In contrast, the sporophyte is made up of diploid cells (two
chromosome sets), These two different stages of the plant life cycle are named
for the types of reproductive cells they produce. Gametophytes produce gametes
(sperm and eggs), while sporophytes produce spores. As reproductive cells,
spores differ from gametes in two ways: A spore can develop into a new organism
without fusing with another cell ( two gametes must fuse to form a zygote) ;
and spores usually have tough coats that enable them to resist harsh
environments.

Figure 16.8 A peat moss bog in Norway. Although mosses are short
in stature, their collective impact on Earth is huge. For example, peat mosses,
or Sphagnum, carpet at least 3% of Earth's terrestrial surface, with greatest
density in high northern latitudes. The accumulation of "peat," the
thick mat of living and dead plants in wetlands, ties up an enormous amount of
organic carbon because peat has an abundance of chemical materials that are not
easily degraded by microbes. That explains why peat makes an excellent fuel as
an alternative to coal and wood. More importantly, the carbon storage by peat
bogs plays an important role in stabilizing Earth's atmospheric carbon dioxide
concentrations, and hence climatr, through the CO2-related greenhouse effect
(see Chapter 7).
Figure 16.9 The two forms of moss: The feathery plant we generally know is a
gametophyte. The stalk of the capsule at it’s tip is the sporophyte. This photo
shows the capsule releasing it’s spores, reproductive cells that can develop
into a new gamotype.

Figure 16.10 Alternation of generations. Plants have life cycles
very different from ours. Each of us is a diploid individual; the only haploid
stages in the human life cycle, as for nearly all animals, are sperm and eggs.
By contrast, plants have alternating generations: Diploid (2n) individuals
(sporophytes) and haploid (nj individuals (gametophytes) generate each other in
the life cycle. In the case of mosses, the gametophyte is the dominant stage.
In fact, the moss sporophyte remains attached to the gametophyte, depending on
its parent for water and nutrients. In other plant groups, this balance is
reversed, with the sporophyte being the more developed of the two generations.
The gametophyte
and sporophyte are alternating generations that take turns producing each
other. Gametophytes produce gametes that unite to form zygotes, which develop
into new sporophytes. And sporophytes produce spores that give rise to new
gametophytes. This type of life cycle, called alternation of generations.
occurs only in plants and certain algae (Figure 16.10). Among plants, mosses
and other bryophytes are unique in having the gametophyte as the dominant
generation - the larger, more obvious plant. We see an increasing dominance of
the sporophyte as the more highly developed generation.
Ferns took terrestrial adaptation to the
next level with the evolution of vascular tissue. However, the sperm of ferns,
like those of mosses, are flagellated and must swim through a film of water to
fertilize eggs. Ferns are also seedless, which helps explain why they do not
dominate most modern terrestrial landscapes. However, of all seedless vascular
plants, ferns are by far the most diverse today with more than 12,000 species.
Most of those species inhabit the tropics, although many species are found in
temperate forests, such as most woodlands of the United States (Figure 16.11 ).
During the Carboniferous period, about
290-360 million years ago, ancient ferns were among a much greater diversity of
seedless plants that formed vast, swampy forests that covered much of what is
now Eurasia and North America (Figure 16.11). At that time, these continents
were close to the equator and had tropical climates. The tropic swamp forests
of the Carboniferous period generated great quantities of organic matter. As
the plants died, they fell into stagnant wetlands and did not decay completely.
Their remains formed thick deposits of organic rubble, or peat. Later, seawater
flooded the swamps, marine sediments covered the peat, and pressure and heat
gradually converted the peat to coal. Coal is black sedimentary rock made up of
fossilize plant material. It formed during several geological periods, but the
most extensive coal beds are derived from Carboniferous deposits. (The name
Carboniferous comes from the Latin carbo, coal and fer-bearing). Coal, oil, and
natural gas are fossil fuels - fuels formed from the remains of extinct
organisms. Fossil fuels are burned to generate much of our electricity. As we
deplete our oil and gas reserves, the use of coal is likely to increase.

Figure 16.11 Ferns (seedless vascular plants) This
species grows on the forest floor in the eastern United States. The
"fiddleheads" in the inset on the right are young fonds (leaves)
ready to unfurl. The fern generation familiar to us is this sporophyte
generation. The inset on the left is the underside of a soiriphyte leaf
specialized for reproduction. The yellow dots consists of spore capsules that
can release numerous tiny spores. The spores develop into gametophytes.
However, you would have to crawl on the forest floor and explore with careful
hands and sharp eyes to find fern gametophytes, tiny plants growing on or just
below the surface.
Figure 16.12 A "coal forest” of the Carboniferous period. This painting, based on fossil evidence,
reconstructs one of the great seedless forests. Most of the large trees with
straight trunks are seedless plants called Iycophytes. On the left, the tree
with numerous feathery branches is another type of seedless plant called a
horsetail. The plants near the base of the trees are ferns. Note the giant
bird-sized dragonfly, which would have made quite a buzz.
“Coal forests” dominated the North
American and Eurasian landscapes until near the end of the Carboniferous
period. At that time, global climate, turned drier and colder, and the vast
swamps began to disappear. This climatic change provided an opportunity for
seed plants, which can complete their life cycles on dry land and withstand
long, harsh winters

Of the earliest
seed plants, the most successful were the gym nosperms, and several kinds grew
along with the seedless plants in the Carboniferous swamps. Their descendants
include the conifers, or cone-bearing plants. Conifers Perhaps you have had the
fun of hiking or skiing through a forest of conifers, the most common
gymnosperms. Pines, firs, spruces, junipers, cedars, and redwoods are all
conifers. A broad band of coniferous forests covers much of northern Eurasia
and North America and extends southward in mountainous regions.
Conifers
are among the tallest, largest, and oldest organisms on Earth. Redwoods, found
only in a narrow coastal strip of northern California, grow to heights of more
than 110 m; only certain eucalyptus trees in Australia are taller. The largest
(most massive) organisms alive are the giant sequoias, relatives of redwoods
that grow in the Sierra Nevada mountains of California. One, known as the
General Sherman tree, has a trunk with a circumference of 26 m and weighs more
than the combined weight of a dozen space shuttles. Bristlecone pines, another
species of California conifer, are among the, oldest organisms alive. One
bristlecone, named Methuselah, is more than 4,600 years old; it was a young
tree when humans invented writing. Nearly all conifers are evergreens, meaning
they retain leaves throughout the year. Even during winter, a limited amount of
photosynthesis occurs on sunny days. And when spring comes, conifers already
have fully developed leaves that can take advantage of the sunnier days. The
needle-shaped leaves of pines and firs are Key also adapted to survive dry
seasons. A thick cuticle covers the
leaf, and the stomata are located in pits, further .reducing water loss.
We get most of
our lumber and paper pulp from the wood of conifers. What we call wood is
actually an accumulation of vascular tissue with lignin, which gives the tree
structural support.
Terrestrial
Adaptations of Seed Plants Compared to ferns, conifers and most other
gymnosperms have three additional adaptations that make survival in diverse
terrestrial habitats possible: (1) further reduction of the gametophyte; (2)
the evolution of pollen; and ( 3) the advent of the seed.
The first
adaptation is an even greater development of the diploid sporophyte compared to
the haploid gametophyte generation (Figure 16.14).
A pine tree or
other conifer is actually a sporophyte with tiny gametophytes living in cones
(Figure 16.15). The gametophytes, though multicellular, are totally dependent
on and protected by the tissues of the parent sporophyte. Some plant biologists
speculate that the shift toward diploidy in land plants was related to the
harmful impact of the sun's ionizing radiation, which causes mutations. This
damaging radiation is more intense on land than in aquatic habitats, where
organisms are somewhat protected by the light-filtering properties of water. Of
the two generations of land plants, the diploid form (sporophyte) may cope
better with mutagenic radiation. A diploid organism homozygous for a particular
essential allele has a "spare tire" in the sense that one copy of the
allele may be sufficient for survival if the other is damaged.

Figure 16.13 Coniferous
forest near Peyto lake in the Canadian Rockies
Figure 16.15 A pine tree, a conifer. The tree bears two types of
cones. The hard, woody ones we usually notice are female cones. Each scale of
the female cone (upper left inset) is actually a modified leaf bearing a pair
of structures called ovules on its upper surface. An ovule contains the egg-producing
female gametophyte. The smaller male cones (lower right inset) produce the male
gametophytes, which are pollen grains. Mature male cones release clouds of
millions of pollen grains. You may have seen yellowish conifer pollen covering
car tops or floating on ponds in the spring. Some of the windblown pollen
manages to land on female cones on trees of the same species. The female cones
generally develop on the higher branches, where they are unlikely to be dusted
with pollen from the same tree. Sperm released by pollen fertilizes eggs in the
ovules of the female cones. The ovules eventually develop into seeds.
A second
adaptation of seed plants to dry land was the evolution of pollen. A pollen
grain is actually the much-reduced male gametophyte. It houses cells that will
develop into sperm. In the case of conifers, wind carries the pollen from male
to female cones, where eggs develop within female garnetophytes (see Figure
16.15). This mechanism for sperm transfer contrasts with the swimming sperm of
mosses and ferns. In seed plants, this use of resistant, airborne pollen to
bring gametes together is a terrestrial adaptation that led to even greater
success and diversity of plants on land.
The third
important terrestrial adaptation of seed plants is, of course, the seed itself.
A seed consists of a plant embryo packaged along with a food supply within a
protective coat. Seeds develop from structures called ovules (Figure 16.16). In
conifers, the ovules are locate on the scales of female cones. Conifers and
other gymnosperms, lacking ovaries, bear their seeds "naked" on the
cone scales ( though the seeds do have protective coats, of course). Once
released from the parent plant, the resistant seed can remain dormant for days,
months, or even years. Under favorable conditions, the seed can then germinate,
its embryo emerging through the seed coat as a seedling. Some seeds drop close
to their parents. Others are carried far by the wind or animals.

Figure 16.16 From ovule to seed. (a) The sporophyte produces
spores within a tissue surrounded by a protective laver called integuments. (b)
The spore develops into a female gametophyte, which produces one or more eggs.
If a pollen grain enters the ovule through a special pore in the integuments,
it discharges sperm cells that fertilize eggs. (c) Fertilization initiates the
transformation of ovule to seed. The fertilized egg (zvgote) develops into an
embryo; the rest of the gametophyte forms a tissue that stockpiles food; and
the integuments of the ovule harden to become the seed coat.
The photograph of the coniferous forest in
Figure 16.13 could give us a somewhat distorted view of today's plant life.
Conifers do cover much land in the northern parts of the globe, but it is the
angiosperms, or flowering plants, that dominate most other regions. There are
about 250,000 angiosperm species versus about 700 species of conifers and other
gymnosperms. Whereas gymnosperms supply most of our lumber and paper,
angiosperms supply nearly all our food and much of our fiber for textiles.
Cereal grains, including wheat, corn, oats, and barley, are flowering plants,
as are citrus and other fruit trees, garden vegetables, cotton, and flax. Fine
hardwoods from flowering plants such as oak, cherry, and walnut trees
supplement the lumber we get from conifers.
Several unique
adaptations account for the success of angiosperms. For example, refinements in
vascular tissue make water transport even more efficient in angiosperms than in
gymnosperms. Of all terrestrial adaptations, however, it is the flower that
accounts for the unparalleled success of the angiosperms.
Flowers.
Fruits. and the Angiosperm Life Cycle No organisms make a showier display
of their sex lives than angiosperms. From roses to dandelions, flowers display
a plant's male and female parts. For most angiosperms, insects and other
animals transfer pollen from the male parts of one flower to the female sex
organs of another flower. This targets the pollen rather than relying on the
capricious winds to blow the pollen between plants of the same species.
A flower is
actually a short stem with four whorls of modified leaves: sepals, petals,
stamens, and carpels (Figure 16.17). At the bottom of the flower are the
sepals, which are usually green. They enclose the flower before it opens (think
of a rosebud). Above the sepals are the petals, which are usually the most
striking part of the flower and are often important in attracting insects and
other pollinators. The actual reproductive structures are multiple stamens and
one or more carpels. Each stamen consists of a stalk bearing a sac called an
anther, the male organ in which pollen grains develop. The carpel consists of a
stalk, the style, with an ovary at the base and a sticky tip known as the
stigma, which traps pollen. The ovary is a protective chamber t containing one
or more ovules, in which the eggs develop.
Figure 16.18
highlights key stages in the angiosperm life cycle. The plant familiar to us is
the sporophyte. As in gymnosperms, the pollen grain is the male gametophyte of
angiosperms. The female gametophyte is located within an ovule, which in turn
resides within a chamber of the ovary. Pollen that lands on the sticky stigma
of a carpel extends a tube down to an ovule and deposits two sperm nuclei
within the female gametophyte. This double fertilization is an
angiosperm characteristic. One sperm cell fertilizes an egg in the female
gametophyte. This produces a zygote, which develops into an embryo. The second
sperm cell fertilizes another female gametophyte cell, which then develops into
a nutrient-storing tissue called endosperm. Double fertilization thus
synchronizes the development of the embryo and food reserves within an ovule.
The whole ovule develops into a seed. The seed's enclosure within an ovary is
what distinguishes angiosperms from the naked-seed condition of gymnosperms.
A fruit is
the ripened ovary of a flower. As seeds are developing from ovules, the ovary
wall thickens, forming the fruit that encloses the seeds. A pea pod is an example of a fruit, with seeds
(mature ovules, the peas) encased in the ripened ovary (the pod). Fruits
protect and help disperse seeds, As Figure 16.19 demonstrates, many angiosperms
depend on animals to disperse seeds. Conversely, most land animals, including
humans, rely on angiosperms as a food source.
Angiosperms
and Agriculture Flowering plants provide nearly all our food. Al1 of our
fruit and vegetable crops are angiosperms. Corn, rice, wheat, and the other
grains are grass fruits. Grains are also the main food source for domesticated
animals, such as cows and chickens. We also grow angiosperms for fiber,
medications, perfumes, and decoration.
Like other
animals, early humans probably collected wild seeds and fruits, Agriculture was
gradually invented as humans began sowing seeds and cultivating plants to have
a more dependable food source. As they domesticated certain plants, humans
began to intervene in plant evolution by selective breeding designed to improve
the quantity and quality of the foods. Agriculture is a unique kind of
evolutionary relationship between plants and animals,

Plant
Diversity as a Nonrenewable Resource
The exploding
human population, with its demand for space and natural resources, is
extinguishing plant species at an unprecedented rate. The problem is especially
critical in the tropics, where more than half the human population lives and
population growth is fastest. Tropical rain forests are being destroyed at a
frightening pace. The most common cause of this destruction is slash-and-burn
clearing of the forest for agricultural use. Fifty million acres, an area about
the size of the state of Washington, are cleared each year, a rate that would
completely eliminate Earth's tropical forests within 25 years. As the forest
disappears, so do thousands of plant species insects and other animals that
depend on these plants are also vanishing.
In all researchers estimate that the destruction of habitat In the rain
forest and other ecosystems is claiming
Biology
and Society
The
Balancing Act of Forest Conservation
With a soft floor
underfoot and the scent of pine needles in the air, few places are as pleasing
to the senses as coniferous forests filled with cone-bearing plants such as
pines, firs, spruces, and redwoods. Today, about 190 million acres of coniferous
forests in the United States, mostly in the western states and Alaska, are
designated national forests. Some of these areas are set aside as unspoiled
wilderness and wildlife habitats. But most national forests are working
forests, managed by the U.S. Forest Service for harvesting lumber, grazing,
mining, and public recreation.
Coniferous
forests are highly productive; you probably use products harvested there every
day. For example, conifers provide much of our lumber for building and wood
pulp for paper production. Currently, our demand for wood and paper is so
great-the average U.S. citizen consumes about 50 times more paper than the
average person in less developed nations-that clear-cut areas have become
commonplace (Figure 16.1 ). In many areas, only about 10% of the original
forest remains intact. Some forests have been replanted but the rate of cutting
often exceeds the rate at which new trees can grow. Moreover, many scientists
predict that an increase in global temperatures, which now seems to be
occurring, poses an additional threat to coniferous forests.
The loss of
coniferous forests threatens more than just the trees themselves. The original
forests of North America were more biologically diverse than the forests that
are now regrowing. Balancing the uses of coniferous forests while
simultaneously trying to sustain them for future generations is a formidable
challenge. What can you do? Reducing paper waste, increasing recycling, and
expanding the use of electronic media can all help. The trees that fill
coniferous forests are just one of several major types of vegetation that share
the planet with us.
Fungi
The word fungus
often evokes some unpleasant images. Fungi rot timbers, spoil food, and afflict
humans with athlete's foot and worse maladies. However, ecosystems would
collapse without fungi to decompose dead organisms, fallen leaves, feces, and
other organic materials, thus reCycling vital chemical elements back to the
environment in forms other organisms can assimilate. And you have already
learned that nearly all plants have mycorrhizae, fungus-root associations that
absorb minerals and water from the soil. In addition to these ecological roles,
fungi have been used by humans in various ways for centuries. We eat some fungi
(mushrooms and truffles, for instance), culture fungi to produce antibiotics
and other drugs, add them to dough to make bread rise, culture them in milk to
produce a variety of cheeses, and use them to ferment beer and wine.
Fungi are eukaryotes, and most are
multicellular. They were once grouped with plants. But in fact molecular
studies indicate that fungi and animals probably arose from a common ancestor.
In other words, a mushroom is probably more closely relate to you than it is to
any plant! However, fungi are actually a form of life so distinctive that they
are accorded their own kingdom, the kingdom Fungi (Figure 16.20).
Characteristics
of Fungi
Fungal Nutrition
Fungi are heterotrophs that acquire their nutrients byabsorption. In this mode
of nutrition, small organic molecules are absorbed from the surrounding medium.
A fungus digests food outside its body by secreting powerful hydrolytic enzymes
into the food. The enzymes decompose complex molecules to the simpler compounds
that the fungus can absorb. For example, fungi that are decomposers absorb
nutrients from nonliving organic material, such as fallen logs, animal corpses,
or the wastes of live organisms. Parasitic fungi absorb nutrients from the
cells or body fluids of living hosts. Some of these fungi, such as certain
species infecting the lungs of humans, are pathogenic. In other cases, such as
mycorrhizae, the relationships between fungi and their hosts are mutually
beneficial.

Figure 16.20 A gallery of diverse fungi. (a)
These mushrooms are the reproductive structures of a fungus that absorbs
nutrients as it decomposes compost on a forest floor. (b) Some
mushroom-producing fungi poke up "fairy rings," which can appear on a
lawn overnight. The legendary explanation of these circles is that mushrooms
spring up where fairies have danced in a ring on moonlit nights. Attervvard,
the tired fairies sit down on some of the mushrooms, but toads use other
mushrooms as stools; hence the name toadstools. Biology offers an alternative
explanation. A ring develops at the edge of the main body of the fungus, which
consists of an underground mass of tiny filaments within the ring. The
filaments secrete enzymes that digest soil compost. As the underground fungal
mass grows outward from its center, the diameter of the fairy rings produced at
its expanding perimeter increases annually. Ic) This fungus, Pilobolus,
decomposes animal dung. The bulbs at the tips of the stalks are sacs of spores,
which are reproductive cells. Pilobolus can actually aim these spore sacs. The stalks
bend toward light, where grass is likely to be growing, and then shoot their
spore sacs like cannonballs. Grazing animals eat the spore sacs and scatter the
spores in feces, where the spores grow into new fungi. Id) The fungi we call
molds grow rapidly on their food sources, often on our food sources. The mold
on this orange reproduces asexually by producing chains of microscopic spores
(inset) that are dispersed via air currents. (e) This predatory fungus traps
and feeds on tiny roundworms in the soil. The fungus is equipped with hoops
that can constrict around a worm in less than a second. (f) Yeasts are
unicellular fungi. This yeast cell is reproducing asexually by a process called
budding. For centuries, humans have domesticated yeasts and put their
metabolism to work in breweries and bakeries.
Fungal Structure
Fungi are structurally adapted for their absorptive nutrition. The bodies of
most fungi are constructed of structures called hyphae (singular, hypha).
Hyphae are minute threads composed of tubular , walls surrounding plasma
membranes and cytoplasm. The hyphae form an interwoven mat called a rnyceliurn
(plural, mycelia), which is the feeding network of a fungus (Figure 16.21 ).
Fungal mycelia can be huge, although they usually escape our notice because
they are often subterranean. In 2000,
scientists discovered the mycelium of one humongous fungus in Oregon that is
5.5 km (3.4 miles) in diameter and spreads through 2,200 acres of forest
(equivalent to over 1,600 football fields). This fungus is at least 2,400 years
old and hundreds of tons in weight, qualifying it among Earth's oldest and
largest organisms.
Most fungi are
multicellular, with hyphae divided into cells by cross-walls. The cross-walls
generally have pores large enough to allow ribosomes, mitochondria, and even
nuclei to flow from cell to cell. The cell walls of fungi differ from the
cellulose walls of plants. Most fungi build their cell walls mainly of chitin, a strong but
flexible polysaccharide similar to the chitin found in the external skeletons
of insects.
Mingling with the
organic matter it is decomposing and absorbing, a mycelium maximizes contact
with its food source. Ten cubic centimeters of rich organic soil may contain as
much as a kilometer of hyphae. And a fungal mycelium grows rapidly, adding as
much as a kilometer of hyphae each day as it branches within its food. Fungi
are nonmotile organisms; they cannot run, swim, or fly in search of food. But
the mycelium makes up for the lack of mobility by swiftly extending the tips of
its hyphae into new territory.
Fungal
Reproduction Fungi reproduce by releasing spores that are produced either
sexually or asexually. The output of spores is mind-boggling. For example,
puffballs, which are the reproductive structures of certain fungi, can puff out
clouds containing trillions of spores (see Figure 13.14). Carried by wind or
water, spores germinate to produce mycelia
if they land in a moist place where there is food. Spores thus function
in dispersal and account for the wide geographic distribution of many species
of fungi. The airborne spores of fungi have been found more than 160 km ( 100
miles) above Earth. Closer to home, try leaving a slice of bread out for a week
or two and you will observe the furry mycelia that grow from the invisible
spores raining down from the surrounding air. It's a good thing those
particular molds cannot grow in our lungs.
The
Ecological Impact of Fungi
Fungi have been
major players in terrestrial communities ever since they moved onto land in the
company of plants.
Fungi as Decomposers
Fungi and bacteria are the principal decomposers that keep ecosystems stocked
with the inorganic nutrients essential ; for plant growth. Without decomposers,
carbon, nitrogen, and other elements would accumulate in organic matter. Plants
and the animals they feed would starve because elements taken from the soil
would not be returned.

Figure 16.21 The fungal mycelium The mushroom we see is like an iceberg. It is a reproductive
structure consisting of tightly packed hyphae that extend upward from a much
more massive mycelium of hyphae growing underground. The photos show mushrooms
and the mycelium of cottony threads that decompose organic litter.
Figure 16.22 Parasitic fungi that cause plant disease. (a)
This photo shows American elm trees after the arrival of the parasitic fungus
that causes Dutch elm disease. The fungus evolved with European species of elm
trees, and it is relatively harmless to them. But it is deadly to American
elms. The fungus was accidentally introduced into the United States on logs
sent from Europe to pay World War I debts. Insects called bark beetles carried
the fungus from tree to tree. Since then, the disease has destroyed elm trees
all across North America. (b) The seeds of some kinds of grain, including rye,
wheat, and oats, are sometimes infected with fungal growths. called ergots, the
dark structures on this seed head of rye. Consumption of flour made from
ergot-infested grain can cause gangrene, nervous spasms, burning sensations, hallucinations,
temporary insanity, and death. One epidemic in Europe in the year A.D. 944
killed more than 40,000 people. During the Middle Ages, the disease (ergotism)
became known as Saint Anthony's fire because many of its victims were cared for
by a Catholic nursing order dedicated to Saint Anthony. Several kinds of toxins
have been isolated from ergots. One called lysergic acid is the raw material
from which the hallucinogenic drug LSD is made. Certain other chemical extracts
are medicinal in small doses. One ergot compound is useful in treating high
blood pressure, for example.
Fungi are well adapted as decomposers of
organic refuse. Their invasive hyphae enter the tissues and cells of dead
organic matter and hydrolyze polymers, including tile cellulose of plant cell
walls. A succession of fungi, in concert with bacteria and, in some
environments, invertebrate animals, is responsible for the complete breakdown
of organic litter. The air is so loaded with fungal spores that as soon as a
leaf falls or an insect dies, it is covered with spores and is soon infiltrated
by fungal hyphae.
We may applaud fungi that decompose forest
litter or dung, but it is a different story when molds attack our fruit or our
shower curtains. Between 100/0 and 50% of the world's fruit harvest is lost
each year to fungal attack. And a wood-digesting fungus does not distinguish
between a fallen oak limb and the oak planks of a boat. During the
Revolutionary War, the British lost more ships to fungal rot than to enemy
attack. What's more, soldiers stationed in the tropics during World War II
watched as their tents, clothing, boots, and binoculars were destroyed by
molds. Some fungi can even decompose certain plastics.
Parasitic
Fungi Of the 100,000 known species of fungi, about 30% make their living as
parasites, mostly on or in plants. In some cases, fungi that infect plants have
literally changed landscapes. One species, for example, has eliminated most
American elm trees (Figure 16.22a). Fungi are also serous agricultural pests. Some
species infect grain crops and cause tremtmendous economic losses each year
(Figure 16.22b).
Animals are much
less susceptible to parasitic fungi than are plants Only about 50 species of
fungi are known to be parasitic in humans and other animals. However, their
effects are significant enough to make us take them seriously. Among the
diseases that fungi cause in humans are yeast infections of the lungs, some of
which can be fatal, and vaginal yeast infections. Other fungal parasites
produce a skin disease called ringworm, so named because it appears as circular
red areas on the skin. The ringworm fungi can infect virtually any skin
surface. Most commonly, they attack the feet and cause intense itching and
sometimes blisters. This condition, known as athlete's foot, is highly
contagious but can be treated with various fungicidal preparations.
Commercial
Uses of Fungi It would not be fair to fungi to end our discussion with an
account of diseases. In addition to their positive global impact as decomposers,
fungi also have a number of practical uses for humans.
Figure 16.23 Feeding on fungi. (a) Truffles (the fungal kind, not
the chocolates) are the reproductive structures of fungi that grow with tree
roots as mycorrhizae. Truffles release strong odors that attract mammals and
insects that excavate the fungi and disperse their spores. In some cases, the
odors mimic sex attractants of certain mammals. Truffle hunters traditionally
used pigs to locate their prizes. However, dogs are now more commonly used
because they have the nose for the scent without the fondness for the flavor.
Gourmets describe the complex flavors of truffles as nutty, musky, cheesy, or
some combination of those tastes. At about $400 per pound for truffles, you
probably won't get a chance to do a taste test of your own in the campus
cafeteria. (b) The turquoise streaks in blue cheese and Roquefort are the
mycelia of a specific fungus.
Figure 16.24 Fungal production of an antibiotic. The first
antibiotic discovered was penicillin, which is made by the common mold called
Penicillium. In this petridish, the clear area between the mold and the
bacterial colony is where the antibiotic produced by Penicillium inhibits the
growth of the bacteria, a species of Staphylococcus.
Most of us have eaten
mushrooms, although we may not have realized that we were ingesting the
reproductive extensions of subterranean fungi. Mushrooms are often cultivated
commercially in artificial caves in which cow manure is piled (be sure to wash
your store-bought mushrooms thoroughly). Edible mushrooms also grow wild in
fields, forests, and backyards but so do poisonous ones. There are no simple
rules to help the novice distinguish edible from deadly mushrooms. Only experts
in mushroom taxonamy should dare to collect the fungi for eating.
Mushrooms are not
the only fungi we eat. The fungi called truffles are highly prized by gourmets
(Figure 16.23a). And the distinctive flavors of certain kinds of cheeses come
from the fungi used to ripen them (Figure 16.23b). Particularly important in
food production are unicellular fungi, the yeasts. Yeasts are used in baking,
brewing, and winemaking.
Fungi are
medically valuable as well. Some fungi produce antibiotics that are used to
treat bacterial diseases. In fact, the first antibiotic discovered was
penicillin, which is made by the common mold called Penicillium (Figure 16.24).
As sources of
antibiotics and food, as decomposers, and as partners with plants in
mycorrhizae, fungi play vital roles in life on Earth.
Mutual
Symbiosis
Evolution is not
just and adaptation of individual species. Relationships between species are
also an evolutionary product. Symbiosis is the term used to describe
ecological relationships between organisms of different specie. that are in
direct contact Parasitism; a symbiotic relationship in which one species, the
parasite, benefits while harming its host in the process. The focus here is on mutualism,
symbiosis that benefits both specie.
Eukaryotic cells
evolved from mutual symbiosis among prokaryotes And today, bacteria living in
the roots of certain plants provide nitrogen compounds to their host and
receive food in exchange. We have our own mutually symbiotic bacteria that help
keep our skin healthy and produce certain vitamins in our intestines. Particularly
relevant is the symbiotic association of fungi and plant
roots--mycorrhizaeo--which made life’s move onto land possible.
Lichens,
symbiotic association. of fungi and algae, are striking examples of how two
species can become so merged that the cooperative is essential1ya new
life-form. At a distance, it is easy to mistake lichens for mosses or other
simple plants growing on rocks, rotting logs, trees, roofs, or gravestones
(Figure 16.25). In fact, lichens are not mosses or any kind of plant, nor are
they even individual organisms. A lichen is a symbiotic association of millions
of tiny algae embraced by a mesh of fungal hyphae The photosynthetic algae feed
the fungi The fungal mycelium, in turn, provides a suitable habitat for the
algae, helping to absorb and retain water and minerals. The mutual1stic merger
of partners is so complete that lichens are actual1y named as species, as
though they are individual organisms. Mutualisms such as lichens and
mycorrhizae showcase the web of life that has evolved on Earth.

Figure 16.25 Lichens: symbiotic associations of fungi and algae.
lichens generally grow very slowly, sometimes in spurts of less than a
millimeter per year. You can date the oldest lichens you see here by the
engraving on the gravestone. Elsewhere, there are lichens that are thousands of
years old, rivaling the oldest plants as Earth's elders. The close relationship
between the fungal and algal partners is evident in the microscopic blowup of a
lichen.